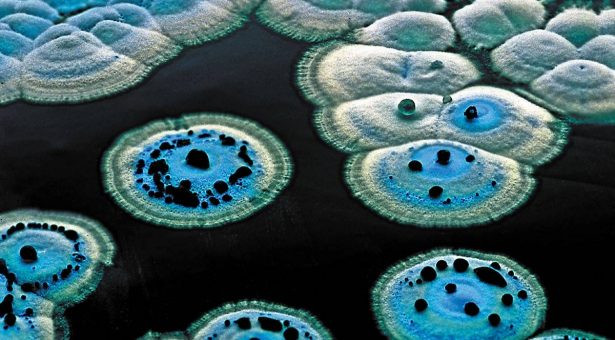
Antibiotic-Producing Bacteria: Nature’s Bioactive Molecule Factories

Antibiotic-Producing Bacteria: Nature’s Bioactive Molecule Factories
Antibiotic-Producing Bacteria: Nature’s Bioactive Molecule Factories
Introduction
Bacteria are not only fundamental to ecosystems but also serve as remarkable producers of bioactive molecules, including antimicrobial compounds. Certain bacterial genera have evolved the ability to synthesize antibiotics as chemical tools to compete and survive in complex microbial communities. These naturally produced molecules have inspired countless applications in biotechnology, industrial microbiology, and molecular research.
The Role of Streptomyces in Antibiotic Production
Among antibiotic-producing bacteria, the genus Streptomyces stands out for its extraordinary capacity to produce diverse antimicrobial compounds. These soil-dwelling bacteria synthesize molecules such as streptomycin, tetracycline, and chloramphenicol, which not only help them survive in competitive environments but also have become indispensable in laboratory and industrial applications.
Figure: Streptomyces: Gram-Positive Bacteria Producing Antibiotics, Enzymes, and Bioactive Metabolites
Key Antibiotics Produced
Streptomyces species generate over half of clinically used antibiotics, with actinomycetes contributing about two-thirds of all microbial antibiotics and Streptomyces accounting for roughly 80% of those. Notable examples include streptomycin from S. griseus, tetracycline from S. rimosus and S. aureofaciens, chloramphenicol from S. venezuelae, and erythromycin from S. erythraeus. Newer derivatives like daptomycin, approved by the FDA in 2003, highlight their ongoing relevance.
This image shows Streptomyces colonies on agar, illustrating their characteristic fuzzy growth that coincides with antibiotic production phases.
Ecological and Regulatory Role
In nature, antibiotics help Streptomyces inhibit competitors, especially closely related strains sharing biosynthetic pathways, though production often decreases under nutrient limitation or toxin threats. Regulation involves developmental cues, global regulators like ppGpp, cluster-specific regulators, and even RNases that influence RNA stability and biosynthesis. This "division of labor" within colonies optimizes resource use for metabolite production.
Industrial and Research Importance
Beyond classic antibiotics, Streptomyces yield antihelminthics, anticancer agents, and more, making them biofactories for drug discovery amid rising antimicrobial resistance. Genetic engineering and microbiome studies continue to unlock novel compounds from these prolific producers.
>> You can find there more information about the application of Streptomyces:
Mechanisms of Biosynthesis
Antibiotic production in Streptomyces relies on biosynthetic gene clusters (BGCs) that encode modular enzymes like polyketide synthases (PKS), non-ribosomal peptide synthetases (NRPS), and hybrid systems for stepwise assembly of complex molecules.
These BGCs are tightly regulated by pathway-specific regulators (CSRs) within the cluster, global regulators like ppGpp, and environmental signals such as nutrient limitation or quorum sensing. Genomic mining reveals high BGC diversity across strains, with cryptic clusters activated by mutations or heterologous expression to yield novel compounds.![]()
Regulation Layers
Pathway-specific regulation acts as a master switch for individual antibiotics, while cross-talk between clusters—such as γ-butyrolactones inducing multiple pathways coordinates production. Promoter indels and interactions with co-produced metabolites further modulate output, explaining variability even among closely related strains. Proteomic tools map these dynamics, linking RNases and developmental genes to biosynthesis timing. 
Industrial Applications
Streptomyces serve as biofactories for antibiotics like streptomycin and erythromycin, enzymes, and fine chemicals, with strain engineering boosting yields via mycelial fragmentation or metabolic rewiring. Immobilization and heterologous expression enhance processes, such as acetylisovaleryltylosin production against resistant bacteria. Emerging uses include nanotechnology for drug delivery and anticancer agents.
Biotechnological Advances
Genetic modifications unlock cryptic BGCs for new antibiotics like ADEPs targeting ClpP proteases, addressing resistance. Comparative metabologenomics prioritizes prolific producers, while sustainable fermentations leverage their GRAS-like traits for pharmaceuticals and bioconversions.
Industrial and Biotechnological Applications
- Pharmaceutical Production
Streptomyces fermentation drives large-scale antibiotic manufacturing, such as streptomycin and tetracycline, using optimized submerged cultures in bioreactors that control pH, oxygen, and carbon sources for maximal yields. Strain improvement via mutagenesis and selection often introducing drug resistance mutations has boosted outputs, as seen in salinomycin-producing S. albus reaching 10 mg/mL through ribosomal engineering. Enzymes like amylases and proteases from these bacteria support detergents and food industries. - Synthetic Biology Advances
Engineered pathways in Streptomyces chassis enable "plug-and-play" BGC activation, with tools like CRISPR refactoring cryptic clusters for novel analogs resistant to modern pathogens. Morphological engineering via ssgA overexpression fragments mycelia, cutting viscosity and doubling enzyme yields in S. lividans fermentations while accelerating growth. Heterologous hosts produce complex molecules like erythromycin derivatives unattainable elsewhere. - Environmental Uses
In soil microbiomes, Streptomyces antibiotics regulate community dynamics, inspiring biocontrol agents against plant pathogens and nematodes. Wastewater studies leverage their degradative enzymes for bioremediation of pollutants, while genome mining from extreme environments uncovers resilient strains for sustainable applications. These bacteria's GRAS status positions them for eco-friendly bioconversions.


Emerging Research: Unlocking Hidden Potential
Recent advances in genomics, metabolomics, and synthetic biology are revealing previously unknown antibiotics and bioactive molecules. For instance:
-
Metagenomic sequencing allows scientists to explore the genetic potential of uncultured bacteria.
-
Proteomics and metabolomics help identify new enzyme functions and metabolic pathways.
-
Gene editing tools like CRISPR are used to modify biosynthetic gene clusters, leading to novel antimicrobial compounds with potential industrial uses.
Conclusion
Antibiotic-producing bacteria like Streptomyces are nature’s miniature factories, generating a vast repertoire of bioactive molecules that serve ecological, industrial, and research purposes. By studying these organisms, scientists gain insights into microbial evolution, chemical diversity, and biotechnological innovation. Harnessing the power of bacterial biosynthesis promises to unlock new possibilities in biotechnology and sustainable industrial processes, providing tools and knowledge that go far beyond the laboratory bench.
Recent Posts
-
HPLC Chromatography: Principle, Types, and Applications
HPLC Chromatography: Principle, Types, and Applications Introduction to HPLC Chromatography HPLC Chr …8th Apr 2026 -
Advances in Peptide Synthesis Technologies and Their Applications in Modern Biotechnology
Advances in Peptide Synthesis Technologies and Their Applications in Modern Biotechnology …27th Mar 2026 -
Western Blot
Introduction Western blotting is a fundamental analytical technique widely used in molecular biology …27th Mar 2026